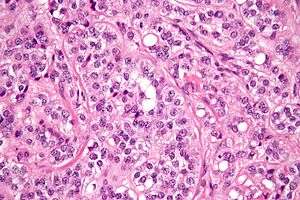

Sertoli cell tumour
| Sertoli cell tumour | |
|---|---|
|
Micrograph of a Sertoli cell tumour. H&E stain. | |
| Classification and external resources | |
| Specialty | oncology |
| ICD-9-CM | 183.0, 256.1 |
| ICD-O | 8631 |
| MeSH | D012707 |
A Sertoli cell tumour, also Sertoli cell tumor (US spelling), is a sex cord-gonadal stromal tumor of a Sertoli cells. Although Sertoli cells normally occur only in the testis, this type of tumor may also rarely occur in the ovary of females.[1]
A tumor that produces both Sertoli cells and Leydig cells is known as a Sertoli-Leydig cell tumor.
Presentation
Due to excess estrogen secreted by these tumours, one-third of male patients may present with a recent history of progressive feminization.
Diagnosis

Presence of an ovarian tumour plus hormonal disturbances suggests a Leydig cell tumour, granulosa cell tumour or thecoma. However, hormonal disturbances, in Leydig tumours, is present in only 2/3 of cases. A conclusive diagnosis is made via histology, as part of a pathology report made during or after surgery. See also sex cord-stromal tumour.
Treatment
The usual treatment is surgery. The surgery in women is usually a fertility-sparing unilateral salpingo-oophorectomy. For malignant tumours, the surgery may be radical and usually is followed by adjuvant chemotherapy, sometimes by radiation therapy. In all cases, initial treatment is followed by surveillance. Because in many cases Leydig cell tumour does not produce elevated tumour markers,[2] the focus of surveillance is on repeated physical examination and imaging.
The prognosis is generally good as the tumour tends to grow slowly and usually is benign: 25% are malignant. For malignant tumours with undifferentiated histology, prognosis is poor.[2]
In non-humans
Sertoli cell tumors are known to occur in other species, including domestic ducks,[3] dogs,[4][5] and horses.
Additional images
-

Micrograph of a Leydig cell tumour.
-

Micrograph of a Leydig cell tumour.
See also
Notes
- ↑ Oliva E, Alvarez T, Young RH (February 2005). "Sertoli cell tumors of the ovary: a clinicopathologic and immunohistochemical study of 54 cases". Am. J. Surg. Pathol. 29 (2): 143–56. doi:10.1097/01.pas.0000149692.21205.9c. PMID 15644771.
- 1 2 Lenhard M, Kuemper C, Ditsch N, Diebold J, Stieber P, Friese K, Burges A (2007). "Use of novel serum markers in clinical follow-up of Sertoli-Leydig cell tumours". Clin. Chem. Lab. Med. 45 (5): 657–61. doi:10.1515/CCLM.2007.120. PMID 17484630.
- ↑ Leach S, Heatley JJ, Pool RR, Spaulding K (December 2008). "Bilateral testicular germ cell-sex cord-stromal tumor in a pekin duck (Anas platyrhynchos domesticus)". J. Avian Med. Surg. 22 (4): 315–9. doi:10.1647/2007-017.1. PMID 19216259.
- ↑ Gopinath D, Draffan D, Philbey AW, Bell R (December 2008). "Use of intralesional oestradiol concentration to identify a functional pulmonary metastasis of canine sertoli cell tumour". J Small Anim Pract. 50 (4): 198–200. doi:10.1111/j.1748-5827.2008.00671.x. PMID 19037884.
- ↑ Vegter AR, Kooistra HS, van Sluijs FJ, van Bruggen LW, Ijzer J, Zijlstra C, Okkens AC (October 2008). "Persistent Mullerian Duct Syndrome in a Miniature Schnauzer Dog with Signs of Feminization and a Sertoli Cell Tumour". Reprod. Domest. Anim. 45 (3): 447–52. doi:10.1111/j.1439-0531.2008.01223.x. PMID 18954385.